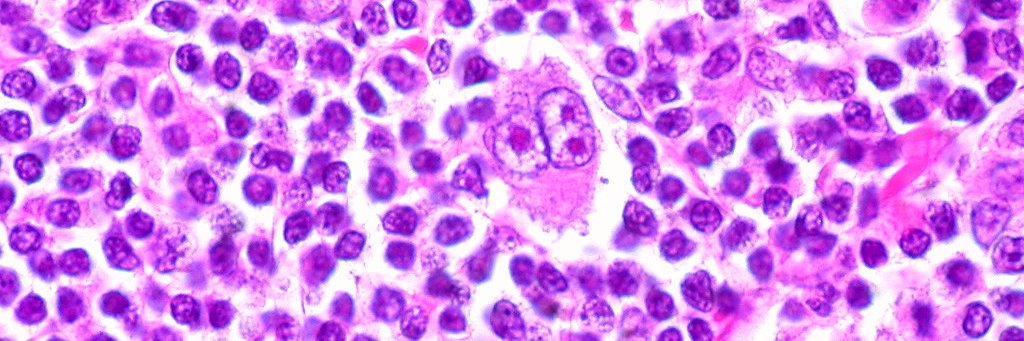
Akiva Diamond banner

@VincentRK @mvmateos @ASH_hematology Really impressive! Honest question- what should be done with all the ongoing (or just opening) trials using Dpd/Dvd as a control arm? Would you still randomize?
English
Akiva Diamond
683 posts

@AkivaDiamond
Malignant Hematologist @BCMCancerCenter focusing on lymphoma patients and research. Views are my own.






























Today is the day! @SWOG 1826 data will be presented at @ASCO plenary, with discussion from @DrLaCasce meetings.asco.org/abstracts-pres…
